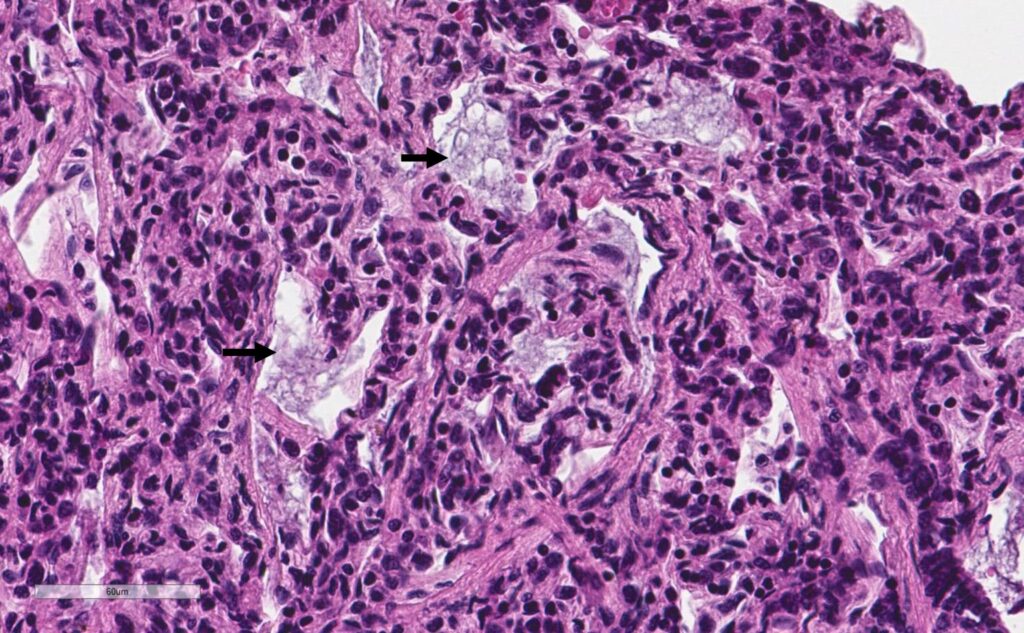
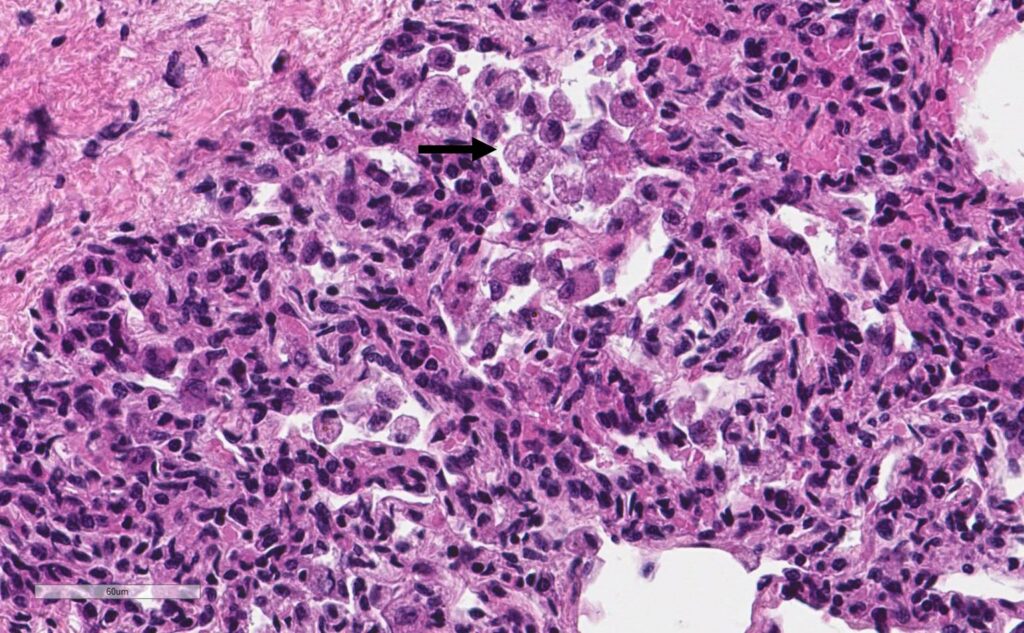

CHAMPS RESOURCES
CHAMPS Resources
A severely malnourished child who died from overwhelming bacterial infection complicated by malaria and anemia
A one-year, eight-month-old female was referred to a regional hospital after two weeks of fever, cough, restlessness, loss of appetite, mouth ulcers, diarrhea, and skin rash. Four days prior, her parents had taken her to a small community health facility where she was treated with antibiotics and pain medication. The mother reported that the child was not brought immediately to the regional hospital because they did not have money for admission and she had hoped to see improvement from treatment received at the community facility. The mother also said she purchased tablets at a pharmacy before visiting the facility to treat the child but could not recall the name of the medication. Unfortunately, neither the community health facility treatment nor the tablets improved the child’s symptoms.
Within the first few hours of hospital admission, the child tested positive for malaria via a Rapid Diagnostic Test. Hemoglobin testing indicated that she was anemic. She was subsequently treated for both conditions but ultimately succumbed to multiple contributing factors just 12 hours after hospital admission.
Uncovering the Causes
CHAMPS laboratory tests revealed presence of a lung infection caused by Klebsiella pneumoniae. This bacterium was also found in samples of the child’s blood and cerebrospinal fluid. Liver specimens showed an accumulation of extra fat cells, which is often indicative of malnutrition. Severely malnourished children are at greater risk of infection which, when affecting organs like the lungs, can lead to death. This child’s underlying malaria and anemia also further weakened her immune system and the ability to fight off bacterial infection.
The CHAMPS team confirmed severe malnutrition as the main underlying cause of death as supported by anthropometric measurements. Malaria and K. pneumoniae were found to be contributing causes of death in this case.
Pathology images
Lung:

Family Follow-up
The CHAMPS team shared resources with the family at follow-up, including education around malaria prevention, healthcare-seeking practices and the risks of self-treating from local pharmacies. They also informed the family about free and low-cost child health support available at the community-level.
Public Health Implications
- Malnutrition Screening: CHAMPS findings underscore the need for early identification and management of nutrition. There was likely a gap in this screening program, as the child was fully vaccinated but was not identified as malnourished at 6.5kg and 1 year 8 months old; the child should have been referred for treatment based on low weight measurements, and monitoring should be able to pick up any children who are missed. There are also free programs for nutrition to which this child could have been referred.
- Traditional Feeding Practices: Aspiration pneumonia is common in this low-income context because, when children are sick, their parents will often force-feed small children a mix of traditional herbs and a local cereal type food called Pap. CHAMPS provides education to healthcare workers and community members about the risks of force-feeding and sharing alternative ways to improve Pap, such as fortifying cereals with locally available nutrients. This kind of fortification is essential to help undernourished children to build strength.
- Malaria Prevention: Education about malaria is critical. This mother lived in a city and her child was fully vaccinated and visited health care facilities often. Nevertheless gaps in general knowledge about malaria and prevention often delay parents from seeking appropriate health care for their children. This could be mitigated by training nurses and patient navigators to provide helpful information about malaria while families are waiting in health care facilities, before and after seeking care. This is a low-cost intervention for an already captive audience.
- Klebsiella pneumoniae: The presence of Klebsiella pneumoniae in several CHAMPS specimens raised alarm about a possible outbreak in this area. This informed a decontamination exercise in the Special Care Baby Unit (SCBU) and involvement of infection prevention control teams, both at country-level and locally. CHAMPS supported the Ministry of Health efforts in a general supervised cleaning of the SCBU unit including disinfecting beds and equipment. Staff were also trained in proper handwashing techniques and glove usage. This message was relayed to all the other SCBUs at quarterly meetings to improve and sustain rigorous cleaning regimens. Random environmental samples were taken at these units that proved the effectiveness of the new infection prevention and control cleaning measures.
Interested in more CHAMPS updates?
Email data@champshealth.org for information about CHAMPS pathology slide images.